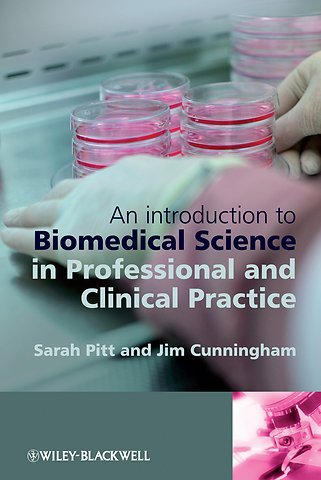
An Introduction to Biomedical Science in Professional and Clinical Practice

An Introduction to Biomedical Science in Professional and Clinical Practice
Samenvatting
Biomedical Science in Professional and Clinical Practice is essential reading for all trainee biomedical scientists looking for an introduction to the biomedical science profession whether they are undergraduates following an accredited biomedical sciences BSc, graduate trainees or experienced staff with overseas qualifications.